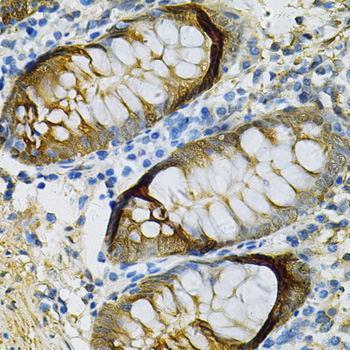

Lane 1: Human MCF-7 cell lysates; Lane 2: Mouse Liver lysates; Lane 3: Mouse kidney lysates probed with SELENBP1 Polyclonal Antibody, Unconjugated (bs-55195R) at 1:1000 dilution and 4˚C overnight incubation. Followed by conjugated secondary antibody incubation at 1:20000 for 60 min at 37˚C.
SELENBP1 Polyclonal Antibody
BS-55195R
ApplicationsImmunoFluorescence, Western Blot, ImmunoCytoChemistry, ImmunoHistoChemistry, ImmunoHistoChemistry Paraffin
Product group Antibodies
TargetSELENBP1
Overview
- SupplierBioss
- Product NameSELENBP1 Polyclonal Antibody
- Delivery Days Customer16
- ApplicationsImmunoFluorescence, Western Blot, ImmunoCytoChemistry, ImmunoHistoChemistry, ImmunoHistoChemistry Paraffin
- Applications SupplierWB(1:300-5000), IHC-P(1:200-400), IF(ICC)(1:50-200), IHC(), IF()
- CertificationResearch Use Only
- ClonalityPolyclonal
- Concentration1 ug/ul
- ConjugateUnconjugated
- Gene ID8991
- Target nameSELENBP1
- Target descriptionselenium binding protein 1
- Target synonymsEHMTO, HEL-S-134P, LPSB, MTO, SBP56, SP56, hSBP, methanethiol oxidase, 56 kDa selenium-binding protein, epididymis secretory sperm binding protein Li 134P
- HostRabbit
- IsotypeIgG
- Protein IDQ13228
- Protein NameMethanethiol oxidase
- Storage Instruction-20°C
- UNSPSC12352203